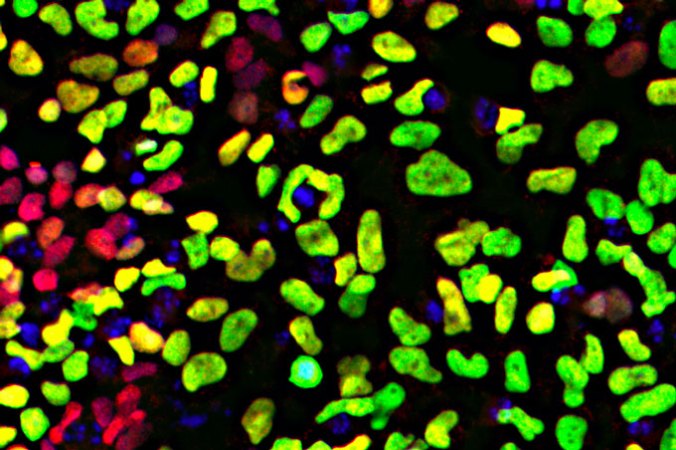
neural crest cells

Modern humans (left in this illustration) have flatter, smaller faces than Neandertals (right) did. Now researchers are implicating a gene that affects movement of some developmentally important cells in that change.
heavypred/DigitalVision Vectors/Getty Images
Domestic animals’ cuteness and humans’ relatively flat faces may be the work of a gene that controls some important developmental cells, a study of lab-grown human cells suggests.
Some scientists are touting the finding as the first real genetic evidence for two theories about domestication. One of those ideas is that humans domesticated themselves over many generations, by weeding out hotheads in favor of the friendly and cooperative (SN: 7/6/17). As people supposedly selected among themselves for tameness traits, other genetic changes occurred that resulted in humans, like other domesticated animals, having a different appearance than their predecessors. Human faces are smaller, flatter and have less prominent brow ridges than Neandertal faces did, for instance.
Domesticated animals look different from their wild counterparts as well. Shorter snouts, curly tails, floppy ears and spotted coats are all traits that tend to pop up in domesticated animals. But until recently, no one had an explanation for this “domestication syndrome.”
Then in 2014, three scientists proposed that as people selected animals for tameness, they also happened to select for genetic changes that slightly hamper movement of some developmentally important cells (SN: 7/14/14). These neural crest cells are present early in embryonic development and migrate to different parts of the embryo where they give rise to many tissues, including bones and cartilage in the face, smooth muscles, adrenal glands, pigment cells and parts of the nervous system. The researchers’ idea was that mild genetic changes might produce neural crest cells that don’t move as well, leading to domestic animals’ cuddlier look.
Both of those big domestication ideas have been just that, with not much hard evidence for or against either. Some studies have suggested that differences in some genes implicated in neural crest cell function might have been important in the domestication of cats (SN: 11/10/14), horses (SN: 4/27/17) and other animals (SN: 5/11/15). But none of those studies explained how those genetic differences led to altered behaviors or looks between wild and domesticated critters.
In the new study, researchers studied cells from people with developmental disorders to learn what makes neural crest cells tick. One gene, BAZ1B, is a neural crest cell boss, the team found, controlling 40 percent of genes active in those cells. Altering levels of BAZ1B’s protein affects how quickly neural crest cells move in lab tests, the scientists report December 4 in Science Advances.
Genes under BAZ1B’s direction are among those that changed both in animals during domestication and in modern humans as they evolved, the researchers also found. Some variants of those genes are found in nearly every modern human, but either weren’t found or were not as prevalent in the DNA of their extinct Neandertal or Denisovan cousins (SN: 9/19/19), the team says.
That all adds up to one thing: “We’re giving the first proof of self-domestication in humans,” says neuroscientist Matteo Zanella of the University of Milan.
But Zanella and his colleagues’ conclusion is a giant leap from their research on cells growing in laboratory dishes, says Kenneth Kosik, a neuroscientist at the University of California, Santa Barbara. “It’s a very seductive paper,” full of interesting ideas and reams of data, he says. But tying human evolution, domestication and development of facial features together based on the activity of one gene is an overinterpretation, Kosik says. “Those kinds of jumps just don’t belong in a scientific paper.”
The researchers made their discoveries by studying cells taken from people with two developmental disorders, each involving a big piece of DNA from chromosome 7 that contains 28 genes, including BAZ1B. People with Williams-Beuren syndrome are missing that piece of DNA from one copy of chromosome 7, leaving them with only one copy of BAZ1B and the other genes. People with the genetic disorder are characteristically talkative, outgoing and not aggressive, and also tend to have especially round faces with short noses, full cheeks and wide mouths with full lips.
One the other hand, people with what’s known as 7q11.23 duplication syndrome have an extra copy of that same piece of DNA, giving them three copies of BAZ1B and the other genes. People with the duplicated DNA have the opposite symptoms: They tend to be aggressive, sometimes have difficulty speaking and have autism-like characteristics that affect their ability to socialize. Their facial features are also exaggerated but different from Williams syndrome.
That combination of behavior extremes and exaggerated facial features seems to indicate that tameness and physical changes go hand in hand just as researchers have proposed for human self-domestication and domestication syndrome in other animals.
BAZ1B was already known to affect neural crest cell function. So probing its actions in cells from people with the syndromes seemed likely to reveal more about how modern human faces evolved, says neuroscientist and coauthor Alessandro Vitriolo, also of the University of Milan. The researchers reasoned that variations in BAZ1B and its protein may slightly impair their function or how much of the protein is produced, leading to slower neural crest cell movement and the characteristics of domestication. But first, the team needed to know whether altering amounts of the BAZ1B protein had any effect on neural crest cells. So the researchers reprogrammed skin cells from people with Williams or the duplication syndrome into stem cells. The scientists then grew the stem cells into neural crest cells.
For comparison, the team also made neural crest cells from people who develop normally and who have the usual two copies of BAZ1B and other 27 genes. Also included were cells from a person with a mild form of Williams syndrome. That person was missing many of the genes in the region, but still had two copies of BAZ1B.
The team also used genetic tricks to reduce levels of the BAZ1B protein, to be sure that any effects were due to the BAZ1B gene and not one of the other nearby genes. When researchers reduced these protein levels in each of the different types of cells, the neural crest cells moved slower. Other genes’ activities were also influenced by the dose of BAZ1B and its protein in cells, the researchers found.
Those results correlating the amount of BAZ1B protein with cellular biology is exactly what would be expected if a neural crest cell gene were responsible for domestication syndrome, says Adam Wilkins, an evolutionary biologist and one of the authors of the 2014 paper. The most convincing bit of evidence for him was the discovery that BAZ1B seems to affect the activity of some genes that have changed in modern humans from the forms seen in Neandertals and Denisovans.
Without that link, the data “would really be just an interesting set of correlations,” says Wilkins, an independent researcher in Berlin. The researchers “have provided some genetic evidence for linking gene activity to paleoanthropological history.” Still, he admits that he has some uneasiness about the study’s sweeping conclusions, though he was not ready to articulate those doubts.
Other researchers are more enthusiastic. “This is the strongest test yet of the human self-domestication hypothesis, and seems to support the idea that humans, like many other animals, have evolved due to selection for friendliness that also shaped other features like our faces,” says Brian Hare, an evolutionary anthropologist at Duke University.